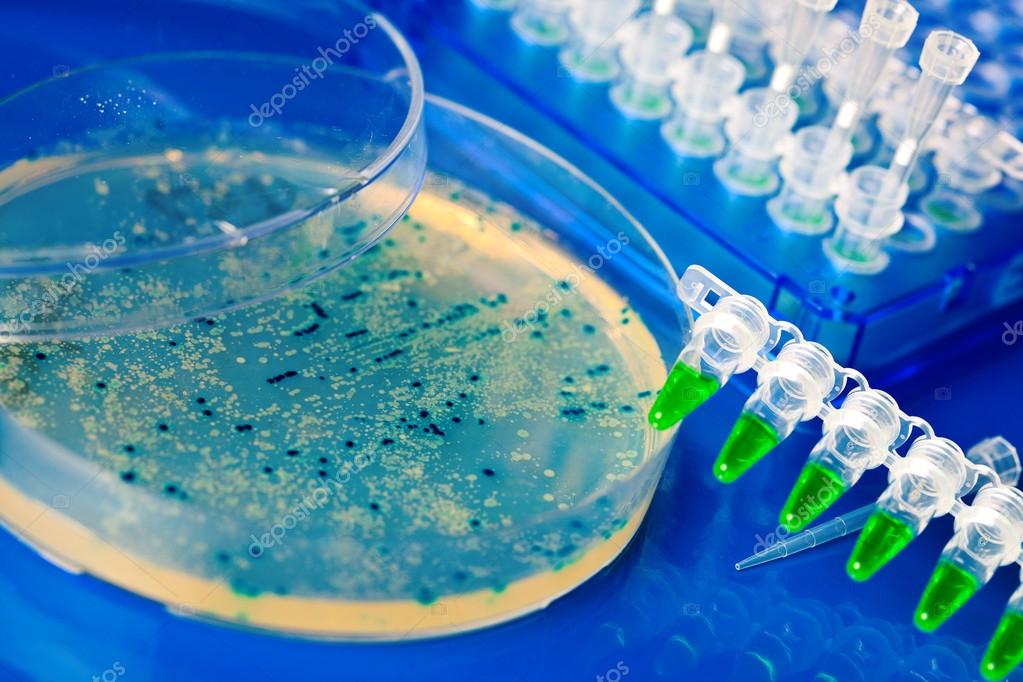
bacterial colony picking for dna cloning | 图库照片 08 anna
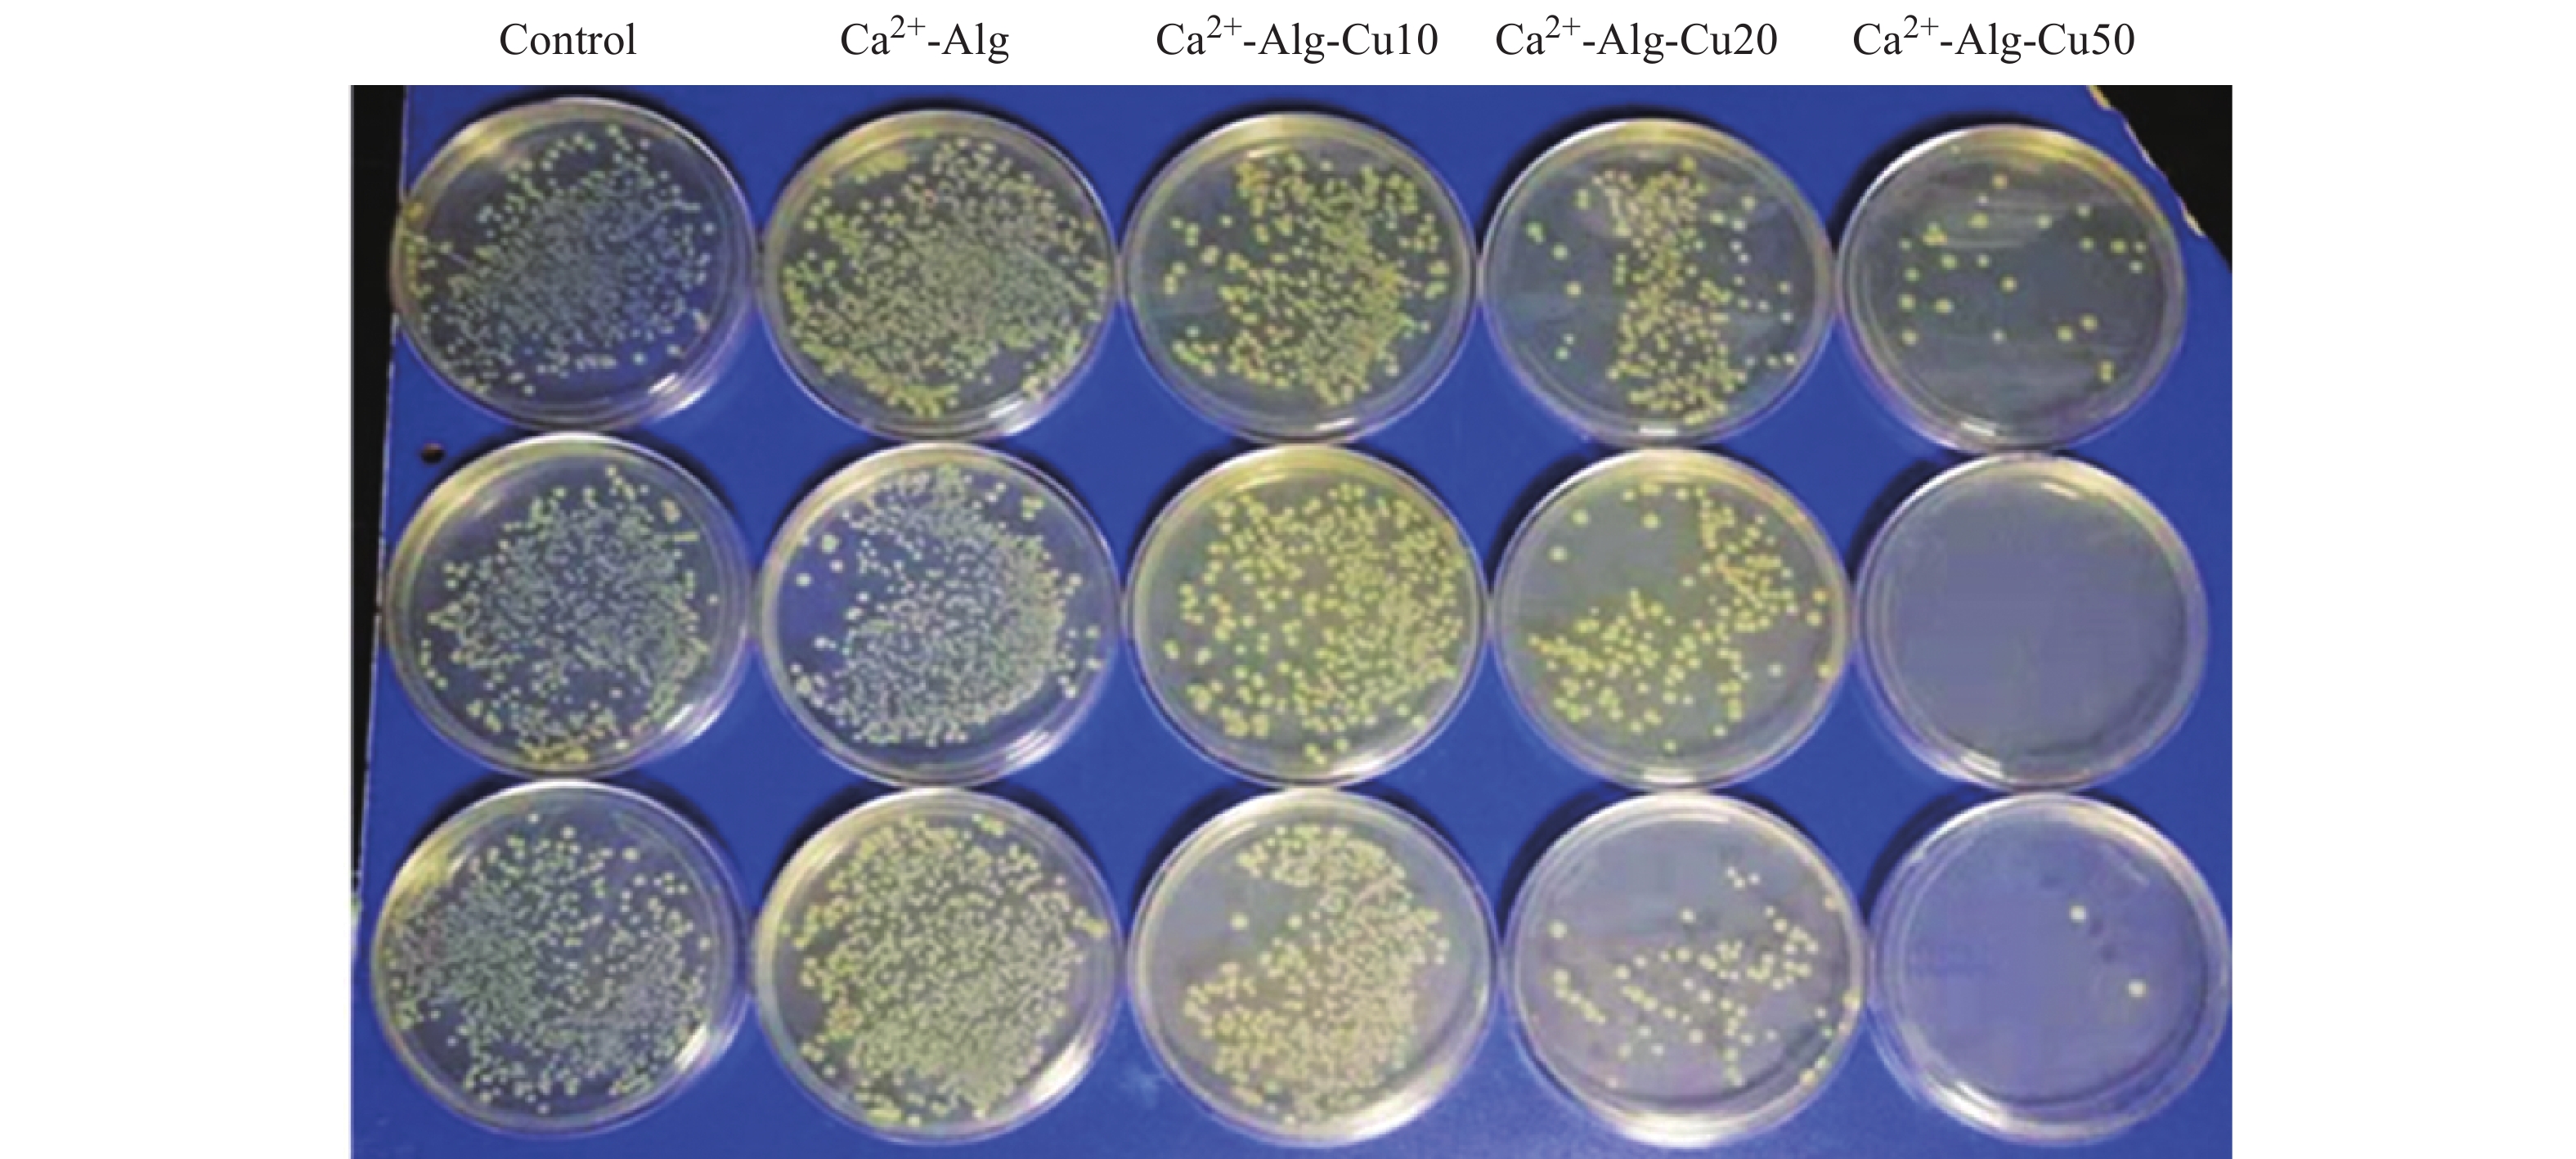
coli colony after high turbidity(1×10 7 cfu/ml) bacterial

bacterialcolony

mit-bacterial-colony-624x416
图片尺寸624x416
bacterial colony picking for dna cloning
图片尺寸450x320
bacterial colony from two-dimensional division to three
图片尺寸792x1023
figure bacterial colony on macconkey agar plate.
图片尺寸353x236
bacterial colony counter
图片尺寸350x402
bacterial colony picking for dna cloning | 图库照片 08 anna
图片尺寸1023x682
colony of pathogen bacteria - 3d render
图片尺寸1500x1245
新书推荐
图片尺寸656x923
computational studies of bacterial colony model
图片尺寸640x526
phase separation in a growing bacterial colony
图片尺寸1280x636
researchers develop computer model of bacterial colony
图片尺寸554x480
computational studies of bacterial colony model
图片尺寸640x516
4colony morphology of aerobic bacterial culture注:需氧细菌培养
图片尺寸1567x589
bacterial colony counter
图片尺寸800x800
computational studies of bacterial colony model
图片尺寸640x511
computational studies of bacterial colony model
图片尺寸640x271
phase separation in a growing bacterial colony
图片尺寸1280x822
computational studies of bacterial colony model
图片尺寸640x516
coli colony after high turbidity(1×10 7 cfu/ml) bacterial
图片尺寸3150x1417
colonyimmunoblottingassayfordetectionofbacterialcellsurfaceor
图片尺寸281x285